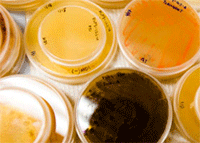
Marine samples being readied for study in the laboratory of William Fenical.

US defence turns to new antibiotics from the sea
By By Mario Aguilera | 21 Sep 2010
In an effort to tap into the vast potential of the oceans as a source for novel medical treatments, the Defense Threat Reduction Agency (DTRA), a part of the Department of Defense (DoD), has awarded San Diego-based Trius Therapeutics, Inc. a four-and-a-half year contract worth up to $29.5 million to collaborate with Scripps Institution of Oceanography at UC San Diego for the development of novel antibiotics directed against microorganisms that cause serious infections.
Trius will use its proprietary Focused Antisense Screening Technology (FAST) to identify the targets of antibacterial compounds from marine natural product libraries discovered by William Fenical, Distinguished Professor of Oceanography at Scripps Institution of Oceanography and Director of Scripps' Center for Marine Biotechnology and Biomedicine.
Trius will use its proprietary Focused Antisense Screening Technology (FAST) to identify the targets of antibacterial compounds from marine natural product libraries discovered by William Fenical, Distinguished Professor of Oceanography at Scripps Institution of Oceanography and Director of Scripps' Center for Marine Biotechnology and Biomedicine.
A pioneer in the field of marine biomedicine, Fenical has led efforts to explore the oceans in search of novel microbial sources that can lead to the development of new cures for a variety of diseases. Expeditions to Fiji, the Bahamas, and just off the Scripps Pier, to name a few destinations, have yielded promising drug compounds to treat cancer and other illnesses. The oceans, which remain largely unexplored, offer a broad diversity of environments that Fenical and his colleagues are examining for novel organisms and unique chemical structures.
Under the new DTRA award, Trius will apply its structure-based drug design capabilities to optimize antibacterial compounds for activity against biodefense pathogens such as Yersinia pestis, Francisella tularensis andBurkholderia pseudomallei. Trius believes that these compounds also will be active against drug-resistant pathogens involved in hospital-acquired infections.
''We are now facing an epidemic because drug resistance is growing at an alarming rate,'' said Fenical. ''The oceans are a huge resource where biodiversity is greatest on our planet. The biomedical potential comes from plants, animals and microbes that have unique genetic compositions.''
''The underlying objective is to identify new compounds for treating infections caused by pathogens that can be used as bioweapons,'' said Jeffrey Stein, chief executive officer of Trius and a Scripps Oceanography alumnus. ''New antimicrobial compounds and mechanisms of action are likely to have a commercial benefit as well, in an age where bacterial pathogens are acquiring resistance to existing antibiotics in both the hospital and in the community.''
Stein added, ''William Fenical and his team at Scripps offer a unique resource in tapping marine microorganisms for the discovery of powerful new antibiotics to address these needs. We are marrying the natural product research resources at Scripps with Trius' expertise in target discovery and structure-based medicinal chemistry in an effort to identify molecules with high potential for product development. Together with Scripps, Trius is leveraging billions of years of evolution inherent in natural products with the most advanced tools in drug design and optimization.''


















